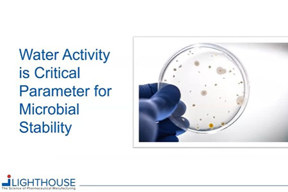

ENVIRONMENTAL MONITORING

Cleanroom Manufacturer Expands Capacity To Meet Industry Needs
AES Clean Technology builds more cleanrooms than anyone else. The market is busy, and so are we... but are we too busy? The answer is a resounding "NO, AES is not too busy!" We plan our cleanroom design, panel manufacturing, and manpower loading and scale as nee...

How Crucial Is Culture Media Selection In Environmental Monitoring?
Explore culture media regulatory requirements, the impact of manufacturing guidelines and media features and specifications on environmental monitoring, and the importance of media supplier selection.

Deliver Contamination Control Solutions To An AUSTAR Customer
In this video interview, the team from AUSTAR UK discuss why and how they worked with Particle Measuring Systems’ (PMS) exclusive UK distributor, EMS Particle Solutions, to provide an AUSTAR Sterility Test Isolator customer with a complete viable and non viable cont...

AES Clean Technology Career Opportunities
AES Clean Technology provides industry-leading modular clean room facilities with career opportunities in design, manufacturing, installation and sales. Hear how our current employees came on board to AES and what they enjoy about their careers.
Water Activity Is A Critical Parameter For Microbial Stability
Learn about USP <1112> Application of Water Activity Determination to Non-sterile Pharmaceutical Products and USP <922> Water Activity, and why water activity is a critical parameter for microbial stability.

Faciliflex Cleanroom Module For Therapeutic Drug Manufacturing
The Faciliflex Module is a transformational new concept in designing cleanrooms for the production of lifesaving therapeutics.

Compressed Gas Risk Assessment: A Significant Step In Your CCS
Discover the importance of compressed gas monitoring in ensuring product quality and compliance with EU GMP standards.

Reduce Production Waste In Pharmaceutical Manufacturing
Learn how cleanroom technicians can perform confident, reliable aseptic microbial monitoring in pharmaceutical manufacturing Grade A and B environments with external vacuum systems.

Data Quality - The Journey Of The Data Management Life Cycle
Sometimes we focus on data while forgetting how poor practices, bad decisions, incorrect definitions, and lack of evaluations effect the outcome. In this webinar, we analyze how to go from “data” to “data quality” to improve your overall contaminat...

Real-Time Information On Microbial Contamination In Pharma Cleanrooms
Watch to learn about the BIOTRAK® Real-Time Viable Pharmaceutical Particle Counter from TSI, which provides real-time information on microbiological contamination in pharmaceutical cleanrooms.

Leveraging Microbial Contamination Monitoring Data For Actionable Insights To Meet And Exceed The Auditor's Expectations
Modern pharmaceutical manufacturers are already generating and managing big data from environmental monitoring; the next step is to create actionable insights and ensure 21CFR11 compliance. This webinar discusses data collection, 21CFR11 data management and the generation...

Viable Monitoring Solutions: Prepare Your Contamination Control Strategy (CCS) For EU GMP ANNEX 1
The New Annex 1 has some critical changes that are important to understand and start applying. While the drafts cover many areas of environmental monitoring in-depth, this webinar by Particle Measuring Systems (PMS) experts focuses on the Viable/Microbial Air Monitoring a...

Particle Measuring Systems' FMS Solution At Argonaut Manufacturing Services
When Argonaut Manufacturing was setting up their new state-of-the-art fill line (a VarioSys line by Bausch & Stroebel and SKAN), they wanted the best contamination monitoring solution to ensure proven product reliability for their customers. The problem was, they had ...

Safety Department At Cleanroom Manufacturer Ensures No One Gets Hurt
AES takes the well-being and safety of all of our team members very seriously. In this video, AES director of EHS Tony Mangabat highlights some of the measures our safety department takes to ensure no one gets hurt at AES.

Understanding ISO 21501-4 – Particle Counter Calibration
In this webinar we review how to be compliant with the most recent particle counter calibration requirements, particle counter terminology, and how a particle counter works in theory.

The Successful Implementation Of A New Aseptic Filling Line
Discover how a Quality by Design approach can streamline the development of new sterile product filling lines, featuring a real-life example illustrating its effectiveness.

Scope 3 Emissions: Cut The Complexity With Creative Collaboration
Delve into the crucial role of Scope 3 emissions in the biopharma industry's sustainability journey, and learn more about the challenges and opportunities of managing these types of emissions.

Single-Use Active Air Microbial Monitor Guidance
In this video, we demonstrate how to tell the BioCapt Single-Use (BCSU) 25/50 LPM from the 100 LPM plates, what their individual applications are, and which active air sources are applicable for use.

Get Your Aseptic Facility Ready For EU GMP Annex 1
Here, we review contamination control strategy (CCS) considerations, the setup of a microbiological environmental monitoring program, and how to optimize the design of hardware and consumables for specific environments.

Airflow Visualization Studies: The Impact Of Annex 1 On Sterility Assurance
Airflow visualization techniques like Smoke Studies and CFD analyses are crucial for contamination control, aiding cleanroom qualification, environmental monitoring, and optimizing contamination control strategies under Annex 1.

Considerations & Steps For Building A Contamination Control Strategy (CCS)
Defining a Contamination Control Strategy (CCS) is unique for each process and requires an intimate understanding of both the process and how to implement an effective strategy.

Customizable Solutions For Cleanroom Facility Monitoring
In pharmaceutical environments, “facility monitoring” or “environmental monitoring” refer to systems that help pharmaceutical manufacturers monitor and control the viable and non viable contamination in their cleanrooms. This includes managing da...

Replacing Settle Plates With Active Air Sampling
Settle plates are a non-validatable method as it is simply based on the physical principle of the downfall of a particle on a surface. We discuss the using active air sampling versus passive air settle plate monitoring in routine environmental monitoring.

The Evolution Of Pharmaceutical Modular Cleanroom Technologies And Project Execution
AES Clean Technology is expediting the delivery of fully functioning cleanrooms. Modular technology allows for repeatable installations of proven systems. New facility projects are time consuming and have thousands of decision points. AES has simplified this process offer...

USP<1788>2022 Revision Summary
Review the latest revisions to the USP<1788>, which has expanded to support a holistic view of finished product contaminants, how they should be investigated, and added flow imaging technologies.

ISO EN 17141 And ISO 14698 Overview
Gain insight into the standard for microbiological monitoring and control, ISO/EN 17141, and how it harmonizes with ISO 14698 parts one and two.

Annex 1 Ready Cleanroom Classification Testing
Discover a portable particle counter that ensures your classification testing complies with the revised EU GMP Annex 1 with updated limits and the ability to define limits that are no longer specified.

A Real-Time Viable Particle Counter To Identify Contamination Source
Here, we introduce a real-time viable particle monitor and how it can quickly identify the source of contamination in pharmaceutical cleanrooms.